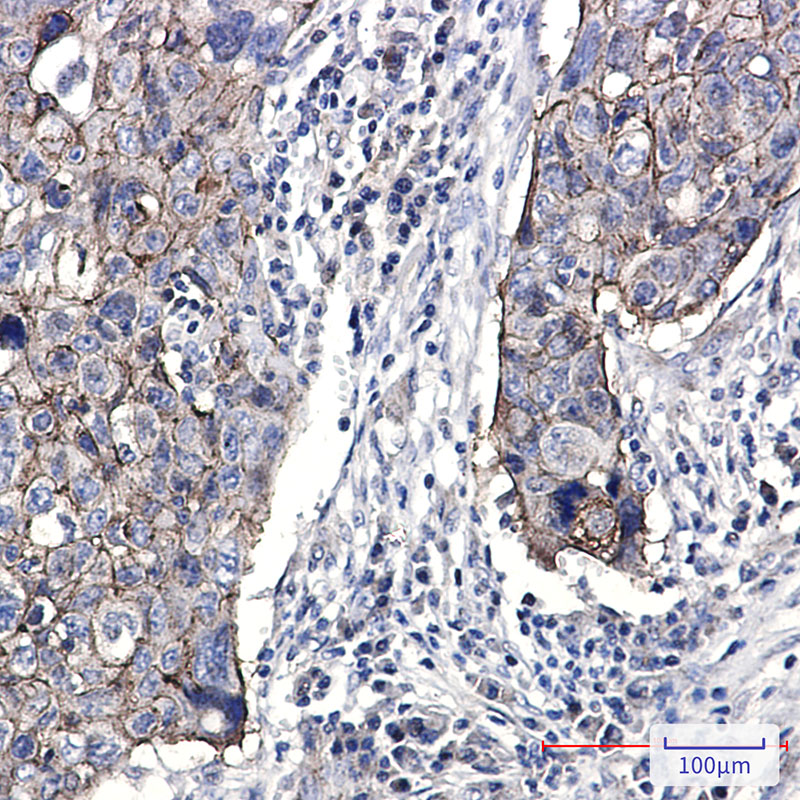

-
分类: 科研抗体货号: P21606别名: CAM; CCM1应用: WB反应种属: Human,Mouse,Rat
-
分类: 科研抗体货号: P21590别名: FLJ25987; MGC8385; ubiquitin B; Ubiquitin; UBCEP1; UBCEP2; RPS27A应用: WB,IHC,IF反应种属: Human,Mouse,Rat
-
分类: 科研抗体货号: P21569别名: My049; ITPase; NTPase; C20orf37; dJ794I6.3; HLC14-06-P应用: WB,IHC反应种属: Human
-
分类: 科研抗体货号: P21589别名: F11R; JAM1; JCAM; Junctional adhesion molecule A; JAM-A; Junctional adhesion molecule 1; JAM-1; Platelet F11 receptor; Platelet adhesion molecule 1; PAM-1; CD321应用: WB,IHC反应种属: Human
-
分类: 科研抗体货号: P21605别名: WVS; ENX1; KMT6; WVS2; ENX-1; EZH2b; KMT6A; EZH2应用: WB,IF反应种属: Human,Mouse,Rat
-
分类: 科研抗体货号: P21568别名: TEMT应用: WB反应种属: Human,Mouse,Rat
-
分类: 科研抗体货号: P21604别名: killin; p53-regulated DNA replication inhibitor; CWS4; KILLIN应用: WB反应种属: Human,Mouse,Rat
-
分类: 科研抗体货号: P21588别名: p50; KBF1; p105; EBP-1; MGC54151; NFKB-p50; NFkappaB; NF-kappaB; NFKB-p105; NF-kappa-B应用: WB,IHC反应种属: Human,Mouse,Rat
-
分类: 科研抗体货号: P21566别名: INHBA; Inhibin beta A chain; Activin beta-A chain; Erythroid differentiation protein; EDF应用: WB反应种属: Human,Rat,Hamster
-
分类: 科研抗体货号: P21603别名: HSET; KNSL2应用: WB,IP,IHC,IF反应种属: Human,Mouse

鄂公网安备42018502007531号
鄂公网安备42018502007531号

